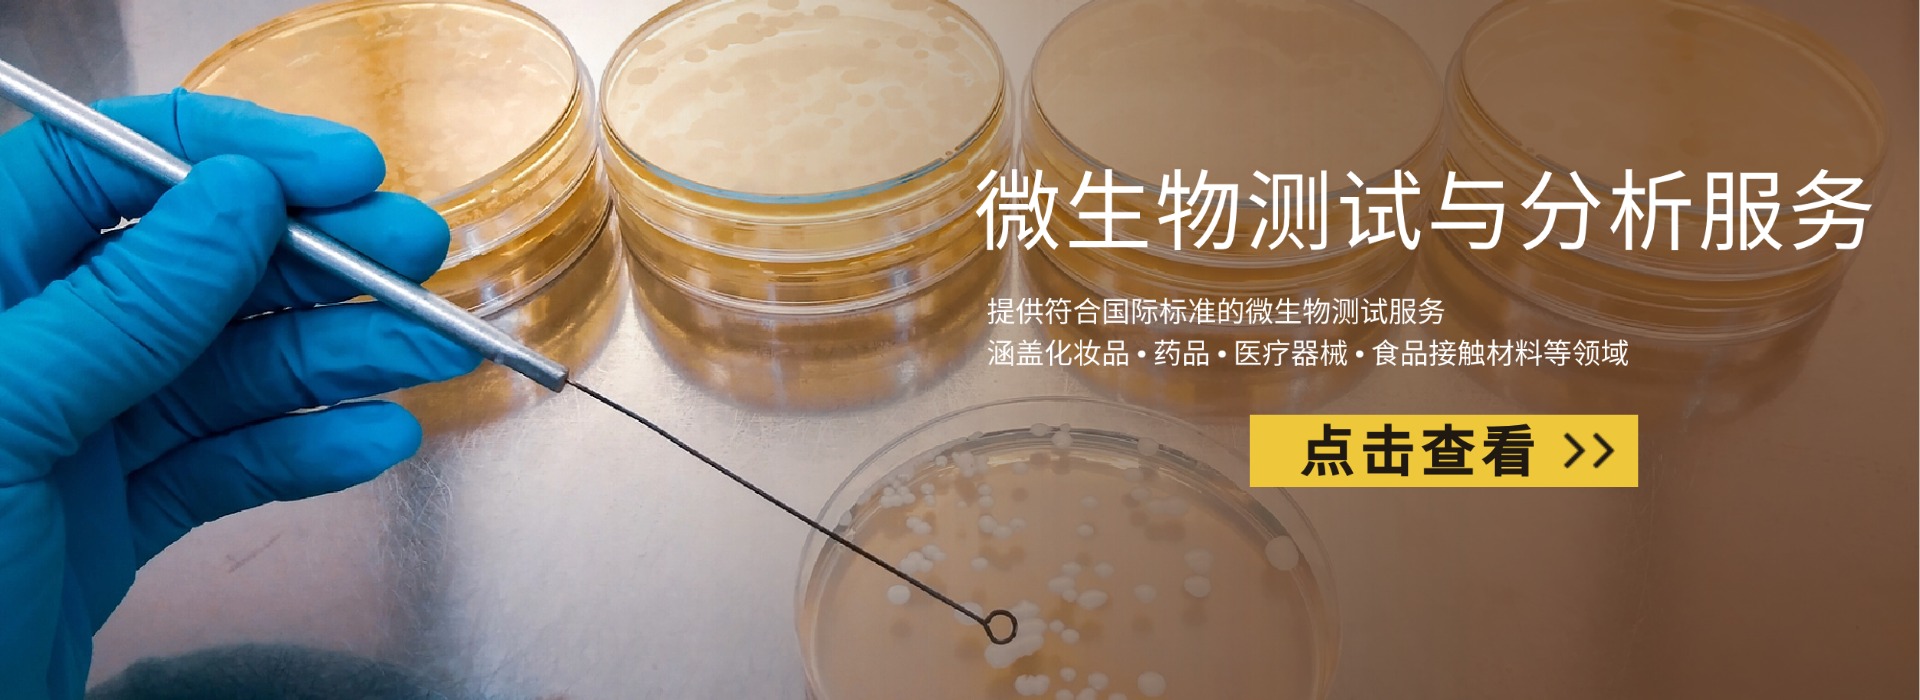
΢(ͼ1)

微生物测试与分析服务
您是否面临以下微生物风险挑战?
? 产品微生物超标:菌落总数、霉菌酵母菌等微生物指标超出限值要求
? 致病菌污染风险:产品中检出铜绿假单胞菌、金黄色葡萄球菌等致病微生物
? 防腐效能不足:产品防腐体系不能有效抑制微生物生长,影响产品保质期
? 生产环境污染:生产环境微生物监控不到位,导致产品污染风险
? 国际市场准入受阻:不了解目标市场微生物限量要求,产品被扣留或召回
我们的微生物测试能力
我们提供全面的微生物测试服务,涵盖以下主要领域:
常规微生物指标:菌落总数、霉菌和酵母菌总数
致病菌检测:铜绿假单胞菌、金黄色葡萄球菌、耐热大肠菌群等
防腐效能测试:挑战性测试,评估产品防腐效果
无菌测试:注射液、植入器械等产品无菌保证
微生物限度测试:非无菌产品微生物污染水平评估
内毒素测试:细菌内毒素含量检测
卫生指标菌:大肠菌群、大肠杆菌等
致病菌筛查:沙门氏菌、李斯特菌等
抗菌性能评估:抗菌材料效果验证
空气微生物:沉降菌、浮游菌监测
表面微生物:人员手部、设备表面微生物监测
水质微生物:工艺用水微生物质量监控
遵循的国际标准与法规
我们的测试严格遵循国际标准与法规要求:
化妆品法规 (EC) No 1223/2009
药典(EP)微生物相关章节
医疗器械指令(MDR)
美国药典(USP)<61>、<62>、<71>等章节
FDA相关微生物要求
化妆品法规要求
ISO 17516:化妆品微生物质量要求
ISO 11737:医疗器械灭菌微生物方法
ISO 16140:食品链微生物学方法验证
我们的服务优势
资质认可
实验室获得ISO 17025认可,具备CMA、CNAS资质。
技术专业
拥有经验丰富的微生物专家团队,提供专业的技术支持。
设备先进
配备全自动微生物鉴定系统、PCR仪等先进设备。
快速响应
优化的工作流程,提供快速的检测周期。
全球认可
检测报告在全球主要市场具有公信力。
深圳谈球吧检验——化学实验室,为您的微生物检测服务提供一站式检测认证解决方案。
我们的服务流程

了解客户需求,制定针对性的测试方案。
规范的样品接收、登记和保存流程。
按照标准方法进行微生物检测。
严格的数据审核和质量控制。
出具准确、清晰的检测报告。
提供技术解读和合规建议。
资质证明与常见问题解答

我司已通过 CMA、CNAS 、IAS资质认可,报告具法律效力。
Q
微生物测试通常需要多长时间?
A
常规微生物测试通常需要5-7个工作日,特殊项目如防腐效能测试可能需要28天或更长时间。
Q
送检样品需要多少数量?
A
样品数量根据测试项目而定,通常每个测试项目需要独立包装的样品3份以上。
Q
如果测试结果不合格,你们能提供什么帮助?
A
我们不仅提供检测服务,还能根据测试结果提供专业的技术分析和改进建议。
Q
你们的检测报告在国际上是否被认可?
A
是的,我们的检测报告基于国际标准,在全球主要市场都具有良好的认可度。
Q
如何保证测试结果的准确性?
A
我们通过标准菌株质控、方法验证、人员比对、设备校准等多重措施确保结果准确可靠。
预约检测
微生物安全是产品质量的重要保障。选择我们,为您提供专业可靠的微生物测试服务,助您的产品顺利进入全球市场。
立即在线咨询,获取微生物测试服务方案和报价
咨询热线:18038017984(V信同号)
